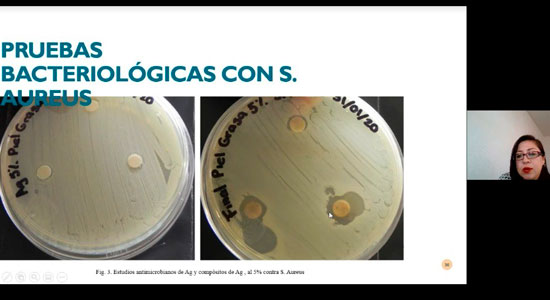

Participan 140 alumnos en sesiones Biomédicas octubre 2020
Departamento de Comunicación - Aranzazú Urbina
La organización Estudiantil SOMIB (Sociedad Mexicana de Ingeniería Biomédica) de la Facultad de Tecnologías de Información de la Universidad De La Salle Bajío, organizó el evento Sesiones Biomédicas, compuestas por una serie de conferencias con profesionales de distintas áreas de la Ingeniería Biomédica.
Pese a la actual situación de pandemia que nos tiene modificando nuestros hábitos, se contó con 140 asistentes, entre alumnos y profesores, de manera virtual. La conferencia que arrancó con esta serie se tituló: “Innovaciones en la biomecánica de la marcha” impartida por el Dr. Irving Rico Restrepo, la cual, tenía como objetivo general, explicar la fisiología, anatomía, tratamientos y prevenciones de la marcha.
Otras conferencias que se abordaron durante la semana de sesiones Biomédicas fueron: “Propiedades bactericidas de bionanocompósitos” por la Dra. Solange Ivette Rivera Manrique; “Procesamiento de imágenes médicas y su relación con los trabajos de investigación en la Ing. Biomédica” por el Ing. Mario Iram García Quezada; “Segmentación de huella digital aplicando técnicas de Machine Learning” por la Mtra. Bibiana Thonamzin Bárcenas Martínez, misma en la que se resolvió el concepto de inteligencia artificial, IA y ML, Machine Learning y sus técnicas, biometría, huella digital, segmentación implementación.
Las conferencias brindaron mucha información y despertaron un interés en los estudiantes a seguir investigando y motivándolos a desarrollar sus conocimientos profesionales. Así se promueven temas de vanguardia y de interés entre la Comunidad Estudiantil, mismos que buscan fortalecer su preparación académica, para brindarles herramientas que permitan crear y generar acciones de impacto en la sociedad.
Pese a la actual situación de pandemia que nos tiene modificando nuestros hábitos, se contó con 140 asistentes, entre alumnos y profesores, de manera virtual. La conferencia que arrancó con esta serie se tituló: “Innovaciones en la biomecánica de la marcha” impartida por el Dr. Irving Rico Restrepo, la cual, tenía como objetivo general, explicar la fisiología, anatomía, tratamientos y prevenciones de la marcha.
Otras conferencias que se abordaron durante la semana de sesiones Biomédicas fueron: “Propiedades bactericidas de bionanocompósitos” por la Dra. Solange Ivette Rivera Manrique; “Procesamiento de imágenes médicas y su relación con los trabajos de investigación en la Ing. Biomédica” por el Ing. Mario Iram García Quezada; “Segmentación de huella digital aplicando técnicas de Machine Learning” por la Mtra. Bibiana Thonamzin Bárcenas Martínez, misma en la que se resolvió el concepto de inteligencia artificial, IA y ML, Machine Learning y sus técnicas, biometría, huella digital, segmentación implementación.
Las conferencias brindaron mucha información y despertaron un interés en los estudiantes a seguir investigando y motivándolos a desarrollar sus conocimientos profesionales. Así se promueven temas de vanguardia y de interés entre la Comunidad Estudiantil, mismos que buscan fortalecer su preparación académica, para brindarles herramientas que permitan crear y generar acciones de impacto en la sociedad.